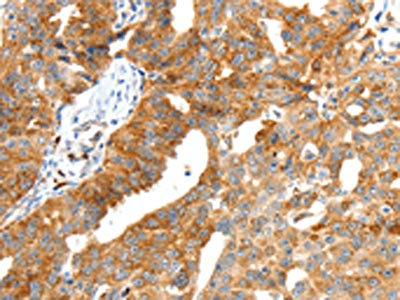

SCT Antibody
-
中文名稱:SCT兔多克隆抗體
-
貨號:CSB-PA797544
-
規格:¥1100
-
圖片:
-
The image on the left is immunohistochemistry of paraffin-embedded Human thyroid cancer tissue using CSB-PA797544(SCT Antibody) at dilution 1/40, on the right is treated with synthetic peptide. (Original magnification: ×200)
-
The image on the left is immunohistochemistry of paraffin-embedded Human ovarian cancer tissue using CSB-PA797544(SCT Antibody) at dilution 1/40, on the right is treated with synthetic peptide. (Original magnification: ×200)
-
-
其他:
產品詳情
-
Uniprot No.:
-
基因名:SCT
-
別名:SCT antibody; Secr antibody; SECR_HUMAN antibody; Secretin antibody; Secretin precursor antibody
-
宿主:Rabbit
-
反應種屬:Human,Mouse,Rat
-
免疫原:Synthetic peptide of Human SCT
-
免疫原種屬:Homo sapiens (Human)
-
標記方式:Non-conjugated
-
抗體亞型:IgG
-
純化方式:Antigen affinity purification
-
濃度:It differs from different batches. Please contact us to confirm it.
-
保存緩沖液:-20°C, pH7.4 PBS, 0.05% NaN3, 40% Glycerol
-
產品提供形式:Liquid
-
應用范圍:ELISA,IHC
-
推薦稀釋比:
Application Recommended Dilution ELISA 1:2000-1:5000 IHC 1:50-1:200 -
Protocols:
-
儲存條件:Upon receipt, store at -20°C or -80°C. Avoid repeated freeze.
-
貨期:Basically, we can dispatch the products out in 1-3 working days after receiving your orders. Delivery time maybe differs from different purchasing way or location, please kindly consult your local distributors for specific delivery time.
-
用途:For Research Use Only. Not for use in diagnostic or therapeutic procedures.
相關產品
靶點詳情
-
功能:Hormone involved in different processes, such as regulation of the pH of the duodenal content, food intake and water homeostasis. Exerts its biological effects by binding to secretin receptor (SCTR), a G-protein coupled receptor expressed in the basolateral domain of several cells. Acts as a key gastrointestinal hormone by regulating the pH of the duodenal content. Secreted by S cells of the duodenum in the crypts of Lieberkuehn and regulates the pH of the duodenum by (1) inhibiting the secretion of gastric acid from the parietal cells of the stomach and (2) stimulating the production of bicarbonate (NaHCO(3)) from the ductal cells of the pancreas. Production of bicarbonate is essential to neutralize the pH and ensure no damage is done to the small intestine by the gastric acid. In addition to regulating the pH of the duodenal content, plays a central role in diet induced thermogenesis: acts as a non-sympathetic brown fat (BAT) activator mediating prandial thermogenesis, which consequentially induces satiation (Probable). Mechanistically, secretin released by the gut after a meal binds to secretin receptor (SCTR) in brown adipocytes, activating brown fat thermogenesis by stimulating lipolysis, which is sensed in the brain and promotes satiation. Also able to stimulate lipolysis in white adipocytes. Also plays an important role in cellular osmoregulation: released into the systemic circulation in response to hyperosmolality and acts at different levels in the hypothalamus, pituitary and kidney to regulate water homeostasis. Also plays a role in the central nervous system, possibly by acting as a neuropeptide hormone: required for hippocampal synaptic function and neural progenitor cells maintenance.
-
基因功能參考文獻:
- CD36 is a major mediator of FA-induced release of CCK and secretin. These peptides contribute to the role of CD36 in fat absorption and to its pleiotropic metabolic effects. PMID: 23233532
- Data suggest that the interaction between secretin peptide residue H1 and secretin receptor residue W274 is most compatible with a hydrophobic interaction. PMID: 22964305
- Secretin effect on increase in transcription of the tyrosine hydroxylase (Th) gene and modulate catecholamine secretion, was tested. PMID: 21597914
- binding and activity of a series of 11 truncated and lactam-constrained secretin(5-27) analogues at the prototypic member of this family, the secretin receptor PMID: 21851058
- secretin significantly inhibited the tumor size and more than doubled tumor latency, which was associated with a decrease in proliferating cell nuclear antigen and an increase in cleaved-caspase 3 expression levels PMID: 19904746
- The purpose of this study was to investigate whether secretin exhibits similar properties in vitro by forming micelles in aqueous solution and interacting with phospholipids PMID: 11814635
- Human VPAC1 receptor selectivity filter; Identification of a critical domain for restricting binding PMID: 12133828
- fine structure in 11p15.5 and sequence variation in patients with autism PMID: 12160732
- human secretin gene is controlled by the Sp1/Sp3 transcription factors ratio and the methylation status of the promoter PMID: 15118068
- Transgenic mouse study suggests a trophic role for secretin on neurons known to be involved in multiple superior functions in the normal brain, and lost in neurodegenerative disorders. PMID: 15610158
- Secretin mRNAs are found in Purkinje cells and secretin-immunoreactivities are localized in both the soma and dendrites of Purkinje cells of human cerebellum. PMID: 15706223
- small heterodimer partner and secretin are potentially co-expressed and lead us to propose a novel regulatory pathway PMID: 16888194
- first pathway is by changing the expression levels of nuclear factor-I C(NFI-C) and secretin proteins while the second pathway is by modifying the phosphorylation status of both NFI-C and secretin proteins via cyclin-dependent kinase 1 PMID: 16888198
- Peptic ulceration may be a hormonal (secfretin) deficiency disease. PMID: 18280672
- These results collectively suggest that variable of tandem repeats could potentially be a functional regulator to control the expression of the human secretin gene in different individuals. PMID: 18566919
- secretin acts through stimulation of presynaptic cholinergic neurons in a vagally mediated pathway. PMID: 19239625
- Bile acids inhibit duodenal secretin expression via orphan nuclear receptor small heterodimer partner (SHP). PMID: 19372104
顯示更多
收起更多
-
亞細胞定位:Secreted.
-
蛋白家族:Glucagon family
-
數據庫鏈接:
Most popular with customers
-
-
YWHAB Recombinant Monoclonal Antibody
Applications: ELISA, WB, IHC, IF, FC
Species Reactivity: Human, Mouse, Rat
-
Phospho-YAP1 (S127) Recombinant Monoclonal Antibody
Applications: ELISA, WB, IHC
Species Reactivity: Human
-
-
-
-
-